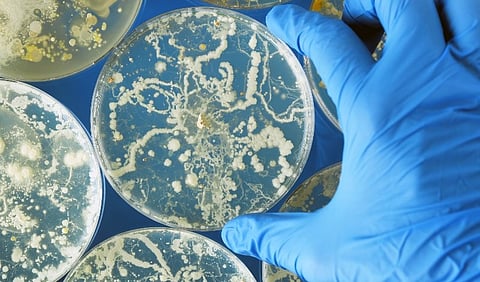

THURSDAY, March 21, 2024 (HealthDay News) -- There were fewer reports of coccidioidomycosis, histoplasmosis, and blastomycosis coinciding with the start of the COVID-19 pandemic, according to research published in the March 21 issue of the U.S. Centers for Disease Control and Prevention Morbidity and Mortality Weekly Report.
Samantha L. Williams, M.P.H., from the CDC in Atlanta, and colleagues analyzed case surveillance data for 2019 to 2021 to describe the epidemiologic characteristics of cases of coccidioidomycosis, histoplasmosis, and blastomycosis during the COVID-19 pandemic.
A total of 59,655 coccidioidomycosis cases, 3,595 histoplasmosis cases, and 719 blastomycosis cases were reported to the CDC during the study period. The researchers found that fewer cases of each disease occurred in spring versus other seasons in 2020, and most cases occurred in the fall. In 2019 and 2021, cases were seasonally distributed more evenly. There were fewer cases coinciding with the start of the COVID-19 pandemic and an unusually high blastomycosis case fatality rate in 2021 (17 percent versus the usual rates of 8 to 10 percent), indicating that patients' health care-seeking behavior, public health reporting practices, or clinical management of these diseases might have been affected by the pandemic.
"Increased awareness is needed to improve prompt diagnosis and treatment of coccidioidomycosis, histoplasmosis, and blastomycosis, particularly during periods of increased incidence of other respiratory diseases," the authors write.